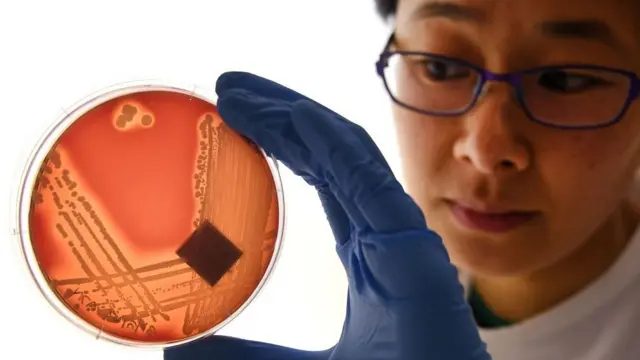
অ্যান্টিবায়োটিক প্রতিরোধী সুপারবাগ নিয়ে গবেষণা করছেন মেলবোর্নের একজন বিজ্ঞানী

অ্যান্টিবায়োটিকের দ্রুত অকার্যকর হয়ে ওঠা ঠেকাতে অক্সফোর্ডে নতুন গবেষণা

ছবির উৎস, Getty Images
ব্রিটেনের অক্সফোর্ড বিশ্ববিদ্যালয় অ্যান্টিবায়োটিকের রোগ প্রতিরোধ ক্ষমতা কমে যাবার বিষয়টি নিয়ে কাজ করার জন্য একটি নতুন গবেষণা কেন্দ্র খুলেছে। নতুন এই গবেষণা সম্পর্কে জানাচ্ছেন বিবিসির সংবাদদাতা শন কফলান।
বিশ্ব জুড়ে বিভিন্ন ধরনের ব্যাকটেরিয়ার মধ্যে যেভাবে অ্যান্টিবায়োটিক ওষুধ প্রতিরোধের ক্ষমতা বেড়ে যাচ্ছে, তাতে বিজ্ঞানীদের মধ্যে উদ্বেগ ক্রমেই বাড়ছে।
অক্সফোর্ড বলছে বিশ্বে স্বাস্থ্য বিষয়ে সবচেয়ে বড় ঝুঁকিগুলোর একটি হল অ্যান্টিবায়োটিক ক্রমশ অকার্যকর হয়ে পড়া। তাদের হিসাব অনুযায়ী অ্যান্টিবায়োটিক কাজ না করার কারণে পৃথিবীতে ইতোমধ্যেই মৃত্যু হচ্ছে ১৫ লাখ মানুষের।
এই গবেষণায় অর্থায়নের জন্য দশ কোটি পাউন্ড অর্থ দান করেছে ইনিওস কেমিক্যাল কোম্পানি।
বিশ্ববিদ্যালয়ের ভাইস চান্সেলার লুইস রিচার্ডসন বলেছেন কোভিড মহামারি বুঝিয়ে দিয়েছে "একটা ঝুঁকি তৈরি হচ্ছে জেনেও তাকে উপেক্ষা করলে তার জন্য কী ধরনের চড়া মূল্য দিতে হয়।"
'বিপদ বাড়ছে'
অ্যান্টিবায়োটিকের "অতি-ব্যবহার এবং অপব্যবহার"এর ফলে রোগজীবাণুর মধ্যে এই ওষুধ প্রতিরোধের শক্তি যেভাবে বেড়ে গেছে তা মোকাবেলা করতে ইনিওস অক্সফোর্ড ইনস্টিটিউট নামের এই গবেষণা প্রতিষ্ঠানে কাজ করবেন ৫০জন গবেষক।
বিশ্ববিদ্যালয় হুঁশিয়ারি দিয়েছে এখনই এই সমস্যা মোকাবেলার উদ্যোগ না নিলে ২০৫০ সালের মধ্যে প্রতি বছর স্বাভাবিকের ওপর একশ কোটি বাড়তি মৃত্যু ঘটবে।
ছবির উৎস, WILLIAM WEST/Getty Images
আরও পড়তে পারেন:
নিয়মিত রুটিন অস্ত্রোপচার এবং "যেসব চিকিৎসায় অ্যান্টিবায়োটিকের ব্যবহার অব্যর্থ বলে ধরে নেয়া হয়" কার্যকর অ্যান্টিবায়োটিক না থাকলে সেগুলো মারাত্মক ঝুঁকিপূর্ণ হয়ে উঠবে।
"অ্যান্টিবায়োটিকের প্রতি প্রতিরোধের কারণে যেভাবে বিপদ বাড়ছে, তা নিয়ে বর্তমান সময়ে সবচেয়ে কম কথাবার্তা বলা হচ্ছে," বলছেন নতুন গবেষণা কেন্দ্রের উপদেষ্টা একজন শল্য চিকিৎসক ডেভিড সুইটম্যান।
"এই ঝুঁকি কাটিয়ে অবস্থা পরিবর্তনের জন্য আমাদের হাতে আসলেই এখন খুবই অল্প সময় রয়েছে। যেটা অভাবনীয় বলে ভাবছি সেটা কিন্তু অবশ্যম্ভাবী হয়ে উঠতে বেশি দেরি নেই," তিনি বলছেন।

অধ্যাপক রিচার্ডসন বলেছেন রোগজীবাণু যেভাবে অ্যান্টিবায়োটিককে অকার্যকর করে দেবার ক্ষমতা গড়ে তুলেছে তাতে "এখুনি পদক্ষেপ নেয়া খুবই জরুরি।"
"এই গবেষণা এই মুহূর্তে খুবই ব্যয়বহুল মনে হতে পারে, কিন্তু এটা না করলে তার যে মূল্য দিতে হবে এটা তার তুলনায় কিছুই নয়," তিনি বলছেন।
ভাইস চান্সেলার বলেছেন কোভিড ভ্যাকসিন উদ্ভাবনে অক্সফোর্ডের সাফল্যের পর এই বিশ্ববিদ্যালয়ের গবেষণার মান এবং বিজ্ঞানীদের দক্ষতার ওপর মানুষের আস্থা বেড়েছে।
মূল্যবান গবেষণার গুরুত্ব
"আমরা পরিস্থিতি বিচার করে এক বছরেরও কম সময়ের মধ্যে এত দ্রুত যে কোভিডের টিকা তৈরি করতে পেরেছি, তার কারণ আমরা গত বিশ বছর ধরে টিকার ওপর নানা মূল্যবান গবেষণার কাজ করেছি," জানান অধ্যাপক রিচার্ডসন।
বিশ্ববিদ্যালয়গুলো যেসব গবেষণার কাজ করে সেগুলো অর্থের যথাযথ ব্যবহার কিনা, সেগুলোর প্রয়োজন আছে কিনা এ নিয়ে নানা সময়ে বিতর্ক ওঠে। বেশি শিক্ষার্থী উচ্চ শিক্ষার দিকে ঝুঁকছে এমন সমালোচনাও মাঝে মধ্যে ওঠে। কিন্তু অধ্যাপক রিচার্ডসন বলছেন মানুষের দৃষ্টিভঙ্গি এখন বদলাচ্ছে।
"ব্রিটেনে গবেষকের সংখ্যা প্রয়োজনের অতিরিক্ত একথা এখন মানুষ আর বলবে না," তিনি বলেন।
কোভিড ভ্যাকসিন উদ্ভাবনের সাফল্য বিশ্ববিদ্যালয়ের মূল্যবান গবেষণার গুরুত্ব তুলে ধরেছে বলে অধ্যাপক রিচার্ডসন মন্তব্য করেছেন।
"এধরনের উদ্ভাবন শুধু মানুষের জীবন বাঁচানোর জন্যই জরুরি নয়, এমনকি অর্থনীতি বাঁচাতে এবং সেই সাথে একটা জাতির সংস্কৃতি রক্ষা জন্যও গুরুত্বপূর্ণ।"
ইনিওস প্রতিষ্ঠানের প্রধান নির্বাহী কোটিপতি সার জিম র্যাটক্লিফ বলেছেন অক্সফোর্ডের সাথে তাদের এই যৌথ উদ্যোগ "বিশ্বের একটা জরুরি চ্যালেঞ্জ মোকাবেলার প্রক্রিয়াকে তরান্বিত করবে"।








